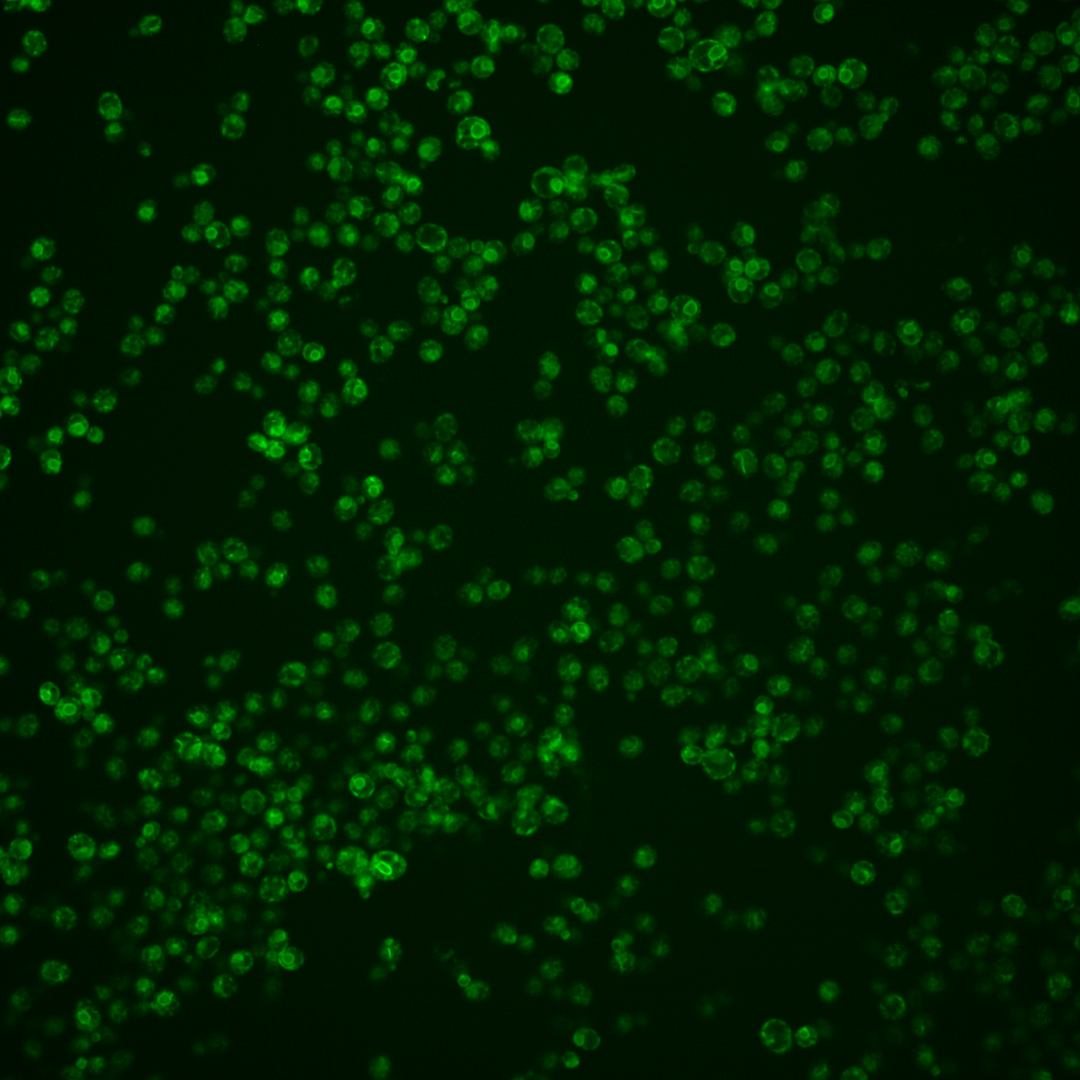
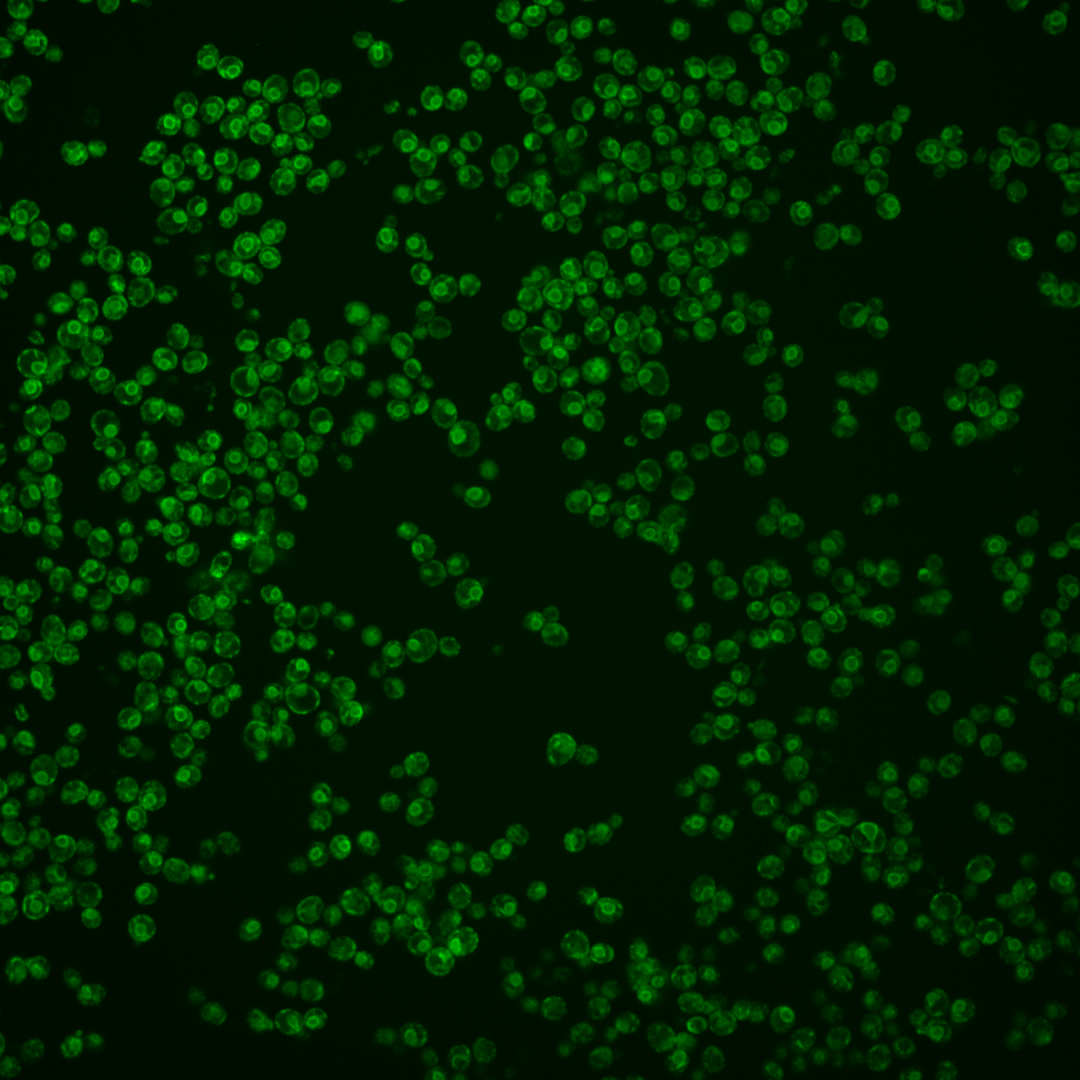
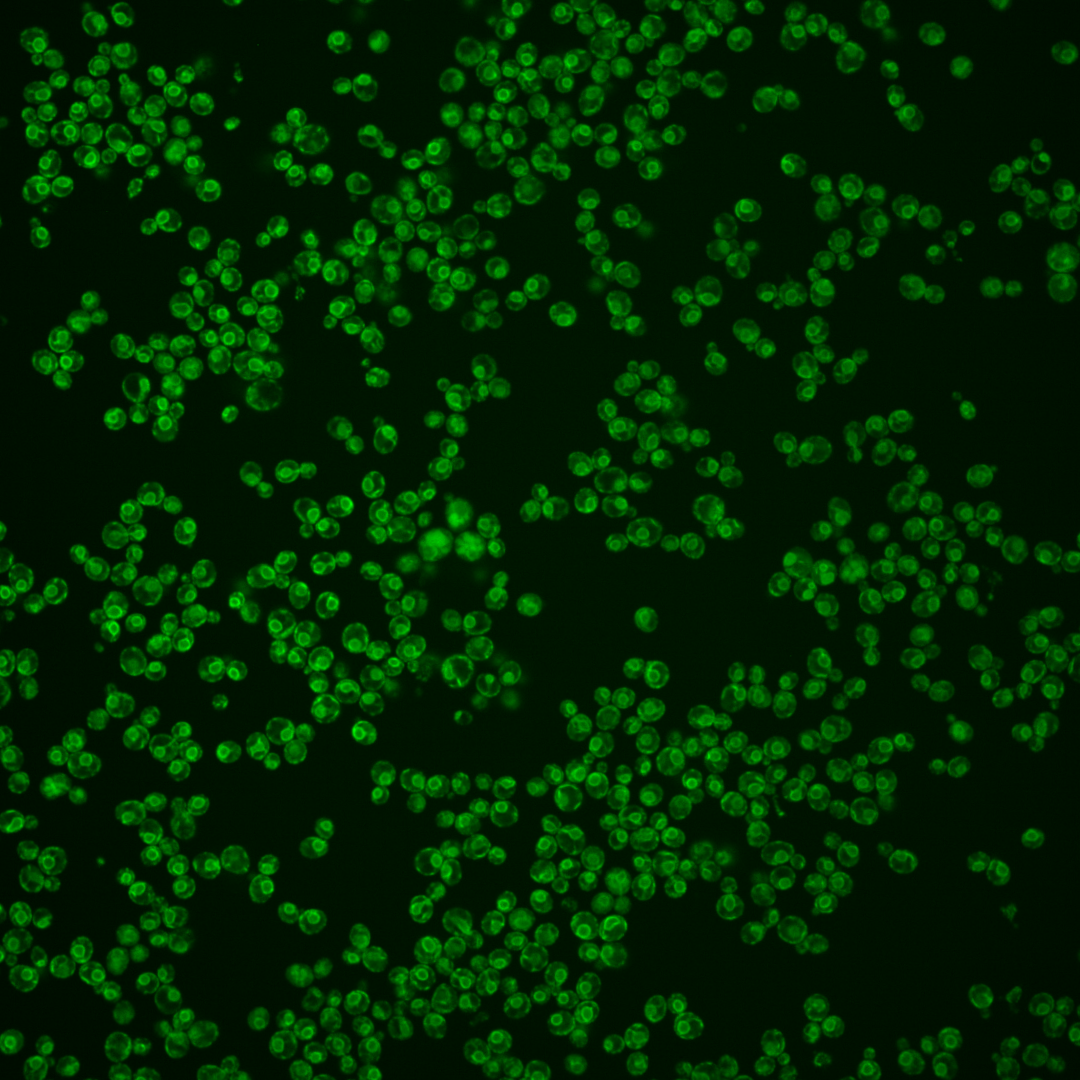
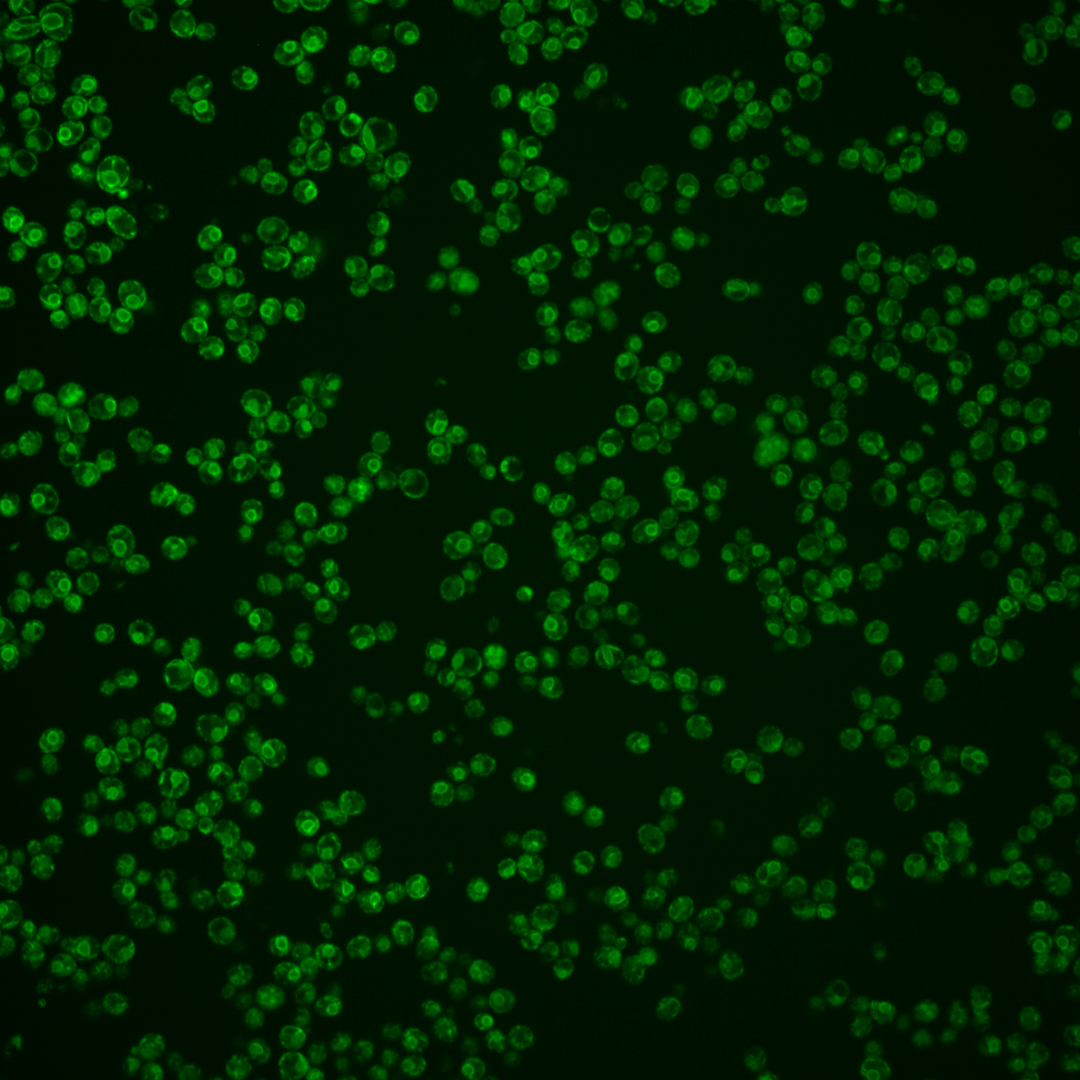

| Standard name | |
|---|---|
| Human Ortholog | |
| Description | ER-membrane protein; subunit of evolutionarily conserved EMC (Endoplasmic Reticulum Membrane Complex) implicated in ERAD (ER-associated degradation) and proper assembly of multi-pass transmembrane (TM) proteins; EMC acts in yeast as an ER-mitochondria tether that interacts with outer membrane protein Tom5 of TOM (Translocase of the Mitochondrial Outer Membrane) complex; suppressor of pma1-7, deletion of SOP4 slows down export of wild-type Pma1p and Pma1-7 from the ER |
Micrographs




















































































Sub-cellular Localization
Yeast GFP Assignment
Protein Abundance
Localization Change
External localization resources
| ensLOC | DeepLoc | |||||||||||||||||||||||
|---|---|---|---|---|---|---|---|---|---|---|---|---|---|---|---|---|---|---|---|---|---|---|---|---|
| Localization | WT1 | WT2 | WT3 | RAP60 | RAP140 | RAP220 | RAP300 | RAP380 | RAP460 | RAP540 | RAP620 | RAP700 | HU80 | HU120 | HU160 | rpd3Δ_1 | rpd3Δ_2 | rpd3Δ_3 | WT1 | WT2 | WT3 | AF100 | AF140 | AF180 |
| Cortical Patches | 7 | 15 | 54 | 50 | 27 | 57 | 29 | 37 | 49 | 43 | 47 | 47 | 31 | 54 | 31 | 21 | 36 | 35 | 3 | 2 | 12 | 13 | 11 | 15 |
| Bud | 2 | 1 | 1 | 2 | 3 | 11 | 4 | 12 | 9 | 15 | 6 | 16 | 3 | 0 | 0 | 3 | 3 | 3 | 0 | 0 | 0 | 0 | 1 | 3 |
| Bud Neck | 0 | 0 | 0 | 0 | 0 | 0 | 0 | 0 | 0 | 0 | 0 | 0 | 0 | 0 | 0 | 0 | 0 | 0 | 0 | 0 | 0 | 1 | 0 | 0 |
| Bud Site | 0 | 0 | 0 | 0 | 0 | 1 | 0 | 0 | 0 | 0 | 0 | 0 | 0 | 0 | 0 | 0 | 0 | 0 | – | – | – | – | – | – |
| Cell Periphery | 6 | 8 | 42 | 32 | 21 | 32 | 24 | 25 | 46 | 41 | 56 | 41 | 89 | 115 | 158 | 51 | 56 | 52 | 0 | 0 | 5 | 5 | 6 | 17 |
| Cytoplasm | 14 | 9 | 29 | 25 | 30 | 59 | 54 | 55 | 55 | 54 | 57 | 42 | 20 | 34 | 45 | 33 | 29 | 30 | 5 | 3 | 2 | 3 | 4 | 4 |
| Endoplasmic Reticulum | 234 | 239 | 445 | 261 | 275 | 368 | 302 | 426 | 306 | 220 | 312 | 289 | 570 | 524 | 505 | 1 | 7 | 3 | 254 | 252 | 485 | 317 | 390 | 521 |
| Endosome | 0 | 0 | 0 | 2 | 2 | 1 | 0 | 0 | 1 | 3 | 0 | 1 | 0 | 0 | 0 | 1 | 0 | 0 | 0 | 0 | 1 | 1 | 1 | 2 |
| Golgi | 4 | 4 | 40 | 51 | 17 | 3 | 0 | 3 | 2 | 1 | 0 | 2 | 30 | 38 | 41 | 69 | 58 | 57 | 2 | 0 | 3 | 7 | 9 | 7 |
| Mitochondria | 2 | 1 | 60 | 40 | 54 | 171 | 122 | 145 | 213 | 221 | 221 | 239 | 1 | 0 | 1 | 12 | 13 | 25 | 2 | 1 | 4 | 12 | 10 | 8 |
| Nucleus | 2 | 1 | 1 | 0 | 0 | 2 | 0 | 2 | 2 | 5 | 0 | 3 | 0 | 1 | 0 | 0 | 0 | 0 | 0 | 0 | 0 | 0 | 0 | 0 |
| Nuclear Periphery | 8 | 2 | 24 | 6 | 10 | 21 | 18 | 46 | 28 | 33 | 38 | 30 | 13 | 8 | 14 | 6 | 9 | 8 | 1 | 0 | 3 | 0 | 2 | 2 |
| Nucleolus | 0 | 0 | 0 | 0 | 0 | 0 | 1 | 2 | 0 | 2 | 0 | 1 | 0 | 0 | 0 | 0 | 0 | 0 | 0 | 0 | 0 | 0 | 0 | 0 |
| Peroxisomes | 0 | 0 | 0 | 0 | 1 | 0 | 0 | 1 | 0 | 0 | 0 | 1 | 0 | 0 | 0 | 0 | 0 | 0 | 0 | 0 | 0 | 0 | 0 | 0 |
| SpindlePole | 0 | 0 | 0 | 0 | 0 | 0 | 0 | 1 | 0 | 0 | 0 | 0 | 0 | 0 | 0 | 0 | 0 | 0 | 0 | 0 | 0 | 0 | 0 | 0 |
| Vac/Vac Membrane | 23 | 11 | 13 | 11 | 34 | 76 | 56 | 126 | 71 | 109 | 28 | 45 | 8 | 35 | 91 | 23 | 22 | 22 | 3 | 3 | 1 | 4 | 8 | 9 |
| Unique Cell Count | 258 | 255 | 506 | 337 | 363 | 585 | 492 | 703 | 564 | 560 | 539 | 549 | 623 | 632 | 711 | 188 | 192 | 188 | 275 | 267 | 525 | 370 | 451 | 597 |
| Labelled Cell Count | 302 | 291 | 709 | 480 | 474 | 802 | 610 | 881 | 782 | 747 | 765 | 757 | 765 | 809 | 886 | 220 | 233 | 235 | 275 | 267 | 525 | 370 | 451 | 597 |
Yeast GFP Assignment
Protein Abundance
| Screen | WT1 | WT2 | WT3 | RAP60 | RAP140 | RAP220 | RAP300 | RAP380 | RAP460 | RAP540 | RAP620 | RAP700 | HU80 | HU120 | HU160 | rpd3Δ_1 | rpd3Δ_2 | rpd3Δ_3 | AF100 | AF140 | AF180 |
|---|---|---|---|---|---|---|---|---|---|---|---|---|---|---|---|---|---|---|---|---|---|
| Mean Cell GFP Intensity (1e-4) | 18.2 | 21.1 | 13.8 | 13.4 | 11.5 | 10.3 | 9.5 | 9.7 | 9.4 | 8.5 | 8.9 | 8.8 | 19.6 | 18.9 | 19.0 | 21.1 | 21.8 | 22.2 | 20.8 | 20.8 | 21.7 |
| Std Deviation (1e-4) | 3.9 | 3.9 | 2.5 | 2.4 | 1.9 | 1.7 | 1.7 | 1.8 | 1.8 | 2.1 | 1.8 | 1.8 | 3.7 | 3.6 | 3.3 | 4.8 | 4.8 | 5.0 | 4.1 | 5.8 | 4.5 |
| Intensity Change (Log2) | – | – | – | -0.04 | -0.27 | -0.42 | -0.54 | -0.51 | -0.55 | -0.7 | -0.63 | -0.64 | 0.51 | 0.46 | 0.46 | 0.62 | 0.66 | 0.69 | 0.59 | 0.6 | 0.66 |
Localization Change
| Localization | RAP60 | RAP140 | RAP220 | RAP300 | RAP380 | RAP460 | RAP540 | RAP620 | RAP700 | HU80 | HU120 | HU160 | rpd3Δ_1 | rpd3Δ_2 | rpd3Δ_3 |
|---|---|---|---|---|---|---|---|---|---|---|---|---|---|---|---|
| Cortical Patches | 1.8 | -1.6 | -0.5 | -2.7 | -3.5 | -1.1 | -1.7 | -1.1 | -1.2 | -3.6 | -1.2 | -4.3 | 0.2 | 2.8 | 2.8 |
| Bud | 0 | 0 | 2.7 | 0 | 2.5 | 0 | 3.3 | 0 | 3.5 | 0 | 0 | 0 | 0 | 0 | 0 |
| Bud Neck | 0 | 0 | 0 | 0 | 0 | 0 | 0 | 0 | 0 | 0 | 0 | 0 | 0 | 0 | 0 |
| Bud Site | 0 | 0 | 0 | 0 | 0 | 0 | 0 | 0 | 0 | 0 | 0 | 0 | 0 | 0 | 0 |
| Cell Periphery | 0.6 | -1.4 | -1.9 | -2.2 | -3.6 | -0.1 | -0.6 | 1.2 | -0.5 | 3.1 | 4.8 | 6.5 | 6.5 | 7.1 | 6.6 |
| Cytoplasm | 1.0 | 1.5 | 2.6 | 3.0 | 1.4 | 2.4 | 2.4 | 2.8 | 1.2 | -2.1 | -0.3 | 0.4 | 4.9 | 4.0 | 4.3 |
| Endoplasmic Reticulum | -4.0 | -4.7 | -9.5 | -9.7 | -10.5 | -12.0 | -16.4 | -10.9 | -12.5 | 2.0 | -2.4 | -7.0 | -21.4 | -20.8 | -21.1 |
| Endosome | 0 | 0 | 0 | 0 | 0 | 0 | 0 | 0 | 0 | 0 | 0 | 0 | 0 | 0 | 0 |
| Golgi | 3.3 | -1.9 | -6.3 | -6.4 | -6.9 | -6.3 | -6.6 | -6.7 | -6.3 | -2.1 | -1.3 | -1.5 | 9.3 | 7.6 | 7.6 |
| Mitochondria | 0 | 1.3 | 7.0 | 5.3 | 4.0 | 9.7 | 10.2 | 10.6 | 11.4 | -8.6 | -8.9 | -9.2 | -2.1 | -2.0 | 0.5 |
| Nucleus | 0 | 0 | 0 | 0 | 0 | 0 | 0 | 0 | 0 | 0 | 0 | 0 | 0 | 0 | 0 |
| Nuclear Periphery | -2.3 | -1.5 | -1.0 | -0.9 | 1.3 | 0.2 | 0.8 | 1.6 | 0.5 | -2.5 | -3.5 | -2.7 | -0.9 | 0 | -0.3 |
| Nucleolus | 0 | 0 | 0 | 0 | 0 | 0 | 0 | 0 | 0 | 0 | 0 | 0 | 0 | 0 | 0 |
| Peroxisomes | 0 | 0 | 0 | 0 | 0 | 0 | 0 | 0 | 0 | 0 | 0 | 0 | 0 | 0 | 0 |
| SpindlePole | 0 | 0 | 0 | 0 | 0 | 0 | 0 | 0 | 0 | 0 | 0 | 0 | 0 | 0 | 0 |
| Vacuole | 0.6 | 4.4 | 6.3 | 5.5 | 8.3 | 6.1 | 8.7 | 2.2 | 4.0 | -1.6 | 2.5 | 6.3 | 5.1 | 4.8 | 4.9 |
External localization resources
Images






























Protein Concentration and Protein Localization Data
| R1 | R2 | R3 | ||||||||||||||||
|---|---|---|---|---|---|---|---|---|---|---|---|---|---|---|---|---|---|---|
| G1 Pre-START | G1 Post-START | S/G2 | Metaphase | Anaphase | Telophase | G1 Pre-START | G1 Post-START | S/G2 | Metaphase | Anaphase | Telophase | G1 Pre-START | G1 Post-START | S/G2 | Metaphase | Anaphase | Telophase | |
| Concentration | – | – | – | – | – | – | – | – | – | – | – | – | – | – | – | – | – | – |
| Actin | – | – | – | – | – | – | – | – | – | – | – | – | – | – | – | – | – | – |
| Bud | – | – | – | – | – | – | – | – | – | – | – | – | – | – | – | – | – | – |
| Bud Neck | – | – | – | – | – | – | – | – | – | – | – | – | – | – | – | – | – | – |
| Bud Periphery | – | – | – | – | – | – | – | – | – | – | – | – | – | – | – | – | – | – |
| Bud Site | – | – | – | – | – | – | – | – | – | – | – | – | – | – | – | – | – | – |
| Cell Periphery | – | – | – | – | – | – | – | – | – | – | – | – | – | – | – | – | – | – |
| Cytoplasm | – | – | – | – | – | – | – | – | – | – | – | – | – | – | – | – | – | – |
| Cytoplasmic Foci | – | – | – | – | – | – | – | – | – | – | – | – | – | – | – | – | – | – |
| Eisosomes | – | – | – | – | – | – | – | – | – | – | – | – | – | – | – | – | – | – |
| Endoplasmic Reticulum | – | – | – | – | – | – | – | – | – | – | – | – | – | – | – | – | – | – |
| Endosome | – | – | – | – | – | – | – | – | – | – | – | – | – | – | – | – | – | – |
| Golgi | – | – | – | – | – | – | – | – | – | – | – | – | – | – | – | – | – | – |
| Lipid Particles | – | – | – | – | – | – | – | – | – | – | – | – | – | – | – | – | – | – |
| Mitochondria | – | – | – | – | – | – | – | – | – | – | – | – | – | – | – | – | – | – |
| None | – | – | – | – | – | – | – | – | – | – | – | – | – | – | – | – | – | – |
| Nuclear Periphery | – | – | – | – | – | – | – | – | – | – | – | – | – | – | – | – | – | – |
| Nucleolus | – | – | – | – | – | – | – | – | – | – | – | – | – | – | – | – | – | – |
| Nucleus | – | – | – | – | – | – | – | – | – | – | – | – | – | – | – | – | – | – |
| Peroxisomes | – | – | – | – | – | – | – | – | – | – | – | – | – | – | – | – | – | – |
| Punctate Nuclear | – | – | – | – | – | – | – | – | – | – | – | – | – | – | – | – | – | – |
| Vacuole | – | – | – | – | – | – | – | – | – | – | – | – | – | – | – | – | – | – |
| Vacuole Periphery | – | – | – | – | – | – | – | – | – | – | – | – | – | – | – | – | – | – |
Sequencing Data
| R1 | R2 | |||||||||
|---|---|---|---|---|---|---|---|---|---|---|
| G1 Post-START | S/G2 | Metaphase | Anaphase | Telophase | G1 Post-START | S/G2 | Metaphase | Anaphase | Telophase | |
| Gene Expression | 108.7753 | 82.5478 | 89.2855 | 108.06 | 89.2864 | 68.8268 | 88.4152 | 84.9762 | 76.7524 | 102.5137 |
| Translational Efficiency | 1.0511 | 0.9662 | 0.966 | 0.7889 | 1.081 | 1.65 | 1.0274 | 1.1494 | 1.1625 | 0.9644 |
Hit Data
| Dataset | Hit |
|---|---|
| Protein Concentration | – |
| Protein Localization | – |
| Gene Expression | ✘ |
| Translational Efficiency | ✘ |
Micrographs
































Cell Count
| R1 | R2 | R1 & R2 | |||||||||
|---|---|---|---|---|---|---|---|---|---|---|---|
| WT | UBP2 | UBP14 | UBP2UBP14 | WT | UBP2 | UBP14 | UBP2UBP14 | WT | UBP2 | UBP14 | UBP2UBP14 |
| 871 | 2146 | 206 | 5 | 1209 | 1313 | 1502 | 3 | 2080 | 3459 | 1708 | 8 |
Protein Abundance
| R1 | R2 | R1 & R2 | ||||||||||
|---|---|---|---|---|---|---|---|---|---|---|---|---|
| WT | UBP2 | UBP14 | UBP2UBP14 | WT | UBP2 | UBP14 | UBP2UBP14 | WT | UBP2 | UBP14 | UBP2UBP14 | |
| Mean | 1016.77 | 1604.60 | 1963.98 | 2494.91 | 1230.95 | 1237.31 | 1780.47 | 429.17 | 1141.26 | 1465.18 | 1802.60 | 1720.26 |
| Standard Deviation | 197.00 | 290.25 | 293.59 | 462.68 | 291.20 | 256.37 | 288.79 | 11.60 | 276.96 | 330.13 | 295.48 | 1064.89 |
| Intensity Change Log 2 | — | 0.658220 | 0.949787 | 1.294994 | — | 0.007435 | 0.532486 | -1.520151 | — | 0.338399 | 0.736291 | 0.379520 |
Localization Score (DeepLoc)
| R1 | R2 | R1 & R2 | ||||||||||
|---|---|---|---|---|---|---|---|---|---|---|---|---|
| WT | UBP2 | UBP14 | UBP2UBP14 | WT | UBP2 | UBP14 | UBP2UBP14 | WT | UBP2 | UBP14 | UBP2UBP14 | |
| Actin | 0.007092 | 0.000439 | 0.000988 | 0.040500 | 0.001651 | 0.001645 | 0.002610 | 0.000030 | 0.003929 | 0.000897 | 0.002414 | 0.025324 |
| Bud Neck | 0.000336 | 0.000091 | 0.002108 | 0.004760 | 0.000916 | 0.002275 | 0.001524 | 0.000001 | 0.000673 | 0.000920 | 0.001594 | 0.002976 |
| Bud Site | 0.006618 | 0.001371 | 0.001772 | 0.081337 | 0.009907 | 0.007790 | 0.010461 | 0.000007 | 0.008530 | 0.003808 | 0.009413 | 0.050838 |
| Cell Periphery | 0.004730 | 0.002826 | 0.005300 | 0.020482 | 0.003329 | 0.006690 | 0.008877 | 0.000117 | 0.003916 | 0.004293 | 0.008446 | 0.012845 |
| Cytoplasm | 0.005742 | 0.001848 | 0.000337 | 0.000404 | 0.005198 | 0.004785 | 0.011082 | 0.000024 | 0.005426 | 0.002963 | 0.009786 | 0.000261 |
| Cytoplasmic Foci | 0.005982 | 0.002043 | 0.000061 | 0.000059 | 0.017045 | 0.005195 | 0.007229 | 0.000004 | 0.012412 | 0.003239 | 0.006365 | 0.000038 |
| Eisosomes | 0.000436 | 0.000086 | 0.000071 | 0.000968 | 0.000071 | 0.000173 | 0.000161 | 0.000116 | 0.000224 | 0.000119 | 0.000150 | 0.000648 |
| Endoplasmic Reticulum | 0.926866* | 0.974561* | 0.953976* | 0.821446* | 0.850468* | 0.942951* | 0.868731* | 0.000002 | 0.882459* | 0.962562* | 0.879012* | 0.513404* |
| Endosome | 0.011023 | 0.005288 | 0.007110 | 0.004848 | 0.023813 | 0.006414 | 0.017975 | 0.000000 | 0.018457 | 0.005716 | 0.016665 | 0.003030 |
| Golgi | 0.007508 | 0.002692 | 0.002044 | 0.002356 | 0.014917 | 0.003431 | 0.013925 | 0.000002 | 0.011814 | 0.002972 | 0.012492 | 0.001473 |
| Lipid Particles | 0.005032 | 0.002886 | 0.002611 | 0.011310 | 0.006338 | 0.005697 | 0.026270 | 0.000019 | 0.005791 | 0.003953 | 0.023416 | 0.007076 |
| Mitochondria | 0.005431 | 0.000525 | 0.000123 | 0.000096 | 0.002871 | 0.001964 | 0.001434 | 0.000012 | 0.003943 | 0.001071 | 0.001276 | 0.000064 |
| Mitotic Spindle | 0.000310 | 0.000251 | 0.000037 | 0.000047 | 0.000274 | 0.000118 | 0.001641 | 0.000110 | 0.000289 | 0.000201 | 0.001447 | 0.000070 |
| None | 0.000784 | 0.001915 | 0.000010 | 0.000176 | 0.004628 | 0.001846 | 0.001345 | 0.999435* | 0.003018 | 0.001889 | 0.001184 | 0.374898* |
| Nuclear Periphery | 0.001268 | 0.000163 | 0.003713 | 0.000723 | 0.000981 | 0.000273 | 0.000828 | 0.000000 | 0.001101 | 0.000205 | 0.001176 | 0.000452 |
| Nuclear Periphery Foci | 0.004457 | 0.000870 | 0.007497 | 0.001456 | 0.010534 | 0.001545 | 0.010567 | 0.000000 | 0.007990 | 0.001126 | 0.010197 | 0.000910 |
| Nucleolus | 0.000061 | 0.000003 | 0.000004 | 0.000002 | 0.000106 | 0.000080 | 0.000016 | 0.000001 | 0.000087 | 0.000032 | 0.000015 | 0.000001 |
| Nucleus | 0.001013 | 0.000062 | 0.000063 | 0.000405 | 0.000587 | 0.000829 | 0.000273 | 0.000003 | 0.000765 | 0.000353 | 0.000248 | 0.000254 |
| Peroxisomes | 0.001510 | 0.000603 | 0.000006 | 0.000013 | 0.000493 | 0.001381 | 0.000789 | 0.000116 | 0.000919 | 0.000898 | 0.000695 | 0.000051 |
| Vacuole | 0.002218 | 0.001103 | 0.010604 | 0.008321 | 0.036528 | 0.003307 | 0.012069 | 0.000000 | 0.022160 | 0.001939 | 0.011893 | 0.005201 |
| Vacuole Periphery | 0.001583 | 0.000374 | 0.001565 | 0.000292 | 0.009345 | 0.001610 | 0.002192 | 0.000000 | 0.006095 | 0.000843 | 0.002116 | 0.000183 |
Localization Changes (T-score)
| R1 | R2 | R1 & R2 | |||||||||||||
|---|---|---|---|---|---|---|---|---|---|---|---|---|---|---|---|
| UBP2_WT | UBP14_WT | UBP2UBP14_WT | UBP2UBP14_UBP2 | UBP2UBP14_UBP14 | UBP2_WT | UBP14_WT | UBP2UBP14_WT | UBP2UBP14_UBP2 | UBP2UBP14_UBP14 | UBP2_WT | UBP14_WT | UBP2UBP14_WT | UBP2UBP14_UBP2 | UBP2UBP14_UBP14 | |
| Actin | NaN | NaN | NaN | NaN | NaN | NaN | NaN | NaN | NaN | NaN | NaN | NaN | NaN | NaN | NaN |
| Bud Neck | NaN | NaN | NaN | NaN | NaN | NaN | NaN | NaN | NaN | NaN | NaN | NaN | NaN | NaN | NaN |
| Bud Site | NaN | NaN | NaN | NaN | NaN | NaN | NaN | NaN | NaN | NaN | NaN | NaN | NaN | NaN | NaN |
| Cell Periphery | NaN | NaN | NaN | NaN | NaN | NaN | NaN | NaN | NaN | NaN | NaN | NaN | NaN | NaN | NaN |
| Cytoplasm | NaN | NaN | NaN | NaN | NaN | NaN | NaN | NaN | NaN | NaN | NaN | NaN | NaN | NaN | NaN |
| Cytoplasmic Foci | NaN | NaN | NaN | NaN | NaN | NaN | NaN | NaN | NaN | NaN | NaN | NaN | NaN | NaN | NaN |
| Eisosomes | NaN | NaN | NaN | NaN | NaN | NaN | NaN | NaN | NaN | NaN | NaN | NaN | NaN | NaN | NaN |
| Endoplasmic Reticulum | NaN | NaN | NaN | NaN | NaN | NaN | NaN | NaN | NaN | NaN | NaN | NaN | NaN | NaN | NaN |
| Endosome | NaN | NaN | NaN | NaN | NaN | NaN | NaN | NaN | NaN | NaN | NaN | NaN | NaN | NaN | NaN |
| Golgi | NaN | NaN | NaN | NaN | NaN | NaN | NaN | NaN | NaN | NaN | NaN | NaN | NaN | NaN | NaN |
| Lipid Particles | NaN | NaN | NaN | NaN | NaN | NaN | NaN | NaN | NaN | NaN | NaN | NaN | NaN | NaN | NaN |
| Mitochondria | NaN | NaN | NaN | NaN | NaN | NaN | NaN | NaN | NaN | NaN | NaN | NaN | NaN | NaN | NaN |
| Mitotic Spindle | NaN | NaN | NaN | NaN | NaN | NaN | NaN | NaN | NaN | NaN | NaN | NaN | NaN | NaN | NaN |
| None | NaN | NaN | NaN | NaN | NaN | NaN | NaN | NaN | NaN | NaN | NaN | NaN | NaN | NaN | NaN |
| Nuclear Periphery | NaN | NaN | NaN | NaN | NaN | NaN | NaN | NaN | NaN | NaN | NaN | NaN | NaN | NaN | NaN |
| Nuclear Periphery Foci | NaN | NaN | NaN | NaN | NaN | NaN | NaN | NaN | NaN | NaN | NaN | NaN | NaN | NaN | NaN |
| Nucleolus | NaN | NaN | NaN | NaN | NaN | NaN | NaN | NaN | NaN | NaN | NaN | NaN | NaN | NaN | NaN |
| Nucleus | NaN | NaN | NaN | NaN | NaN | NaN | NaN | NaN | NaN | NaN | NaN | NaN | NaN | NaN | NaN |
| Peroxisomes | NaN | NaN | NaN | NaN | NaN | NaN | NaN | NaN | NaN | NaN | NaN | NaN | NaN | NaN | NaN |
| Vacuole | NaN | NaN | NaN | NaN | NaN | NaN | NaN | NaN | NaN | NaN | NaN | NaN | NaN | NaN | NaN |
| Vacuole Periphery | NaN | NaN | NaN | NaN | NaN | NaN | NaN | NaN | NaN | NaN | NaN | NaN | NaN | NaN | NaN |
Endocytosis
| Temp | Actin Patch (Sac6-tdTomato) | Cortical Patch (Sla1-GFP) | Late Endosome (Snf7-GFP) | Vacuole (Vph1-GFP) |
|---|---|---|---|---|
| 37℃ | ||||
| RT |
Cell Cycle Omics
CYCLoPs (Sop4-GFP)
| Gene / Allele | Actin Patch (Sac6-tdTomato) | Cortical Patch (Sla1-GFP) | Late Endosome (Snf7-GFP) | Vacuole (Sac6-tdTomato) |
|---|
| Gene | Images |
|---|
| Gene | Images |
|---|
Images are not yet available
Images are not yet available